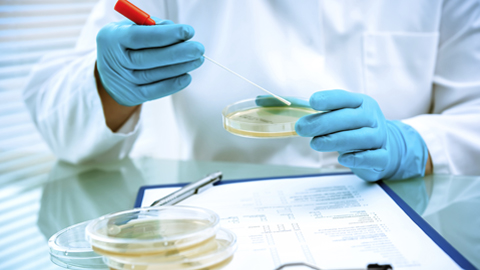
microbiologiaalimentaria

Sala de premsa
Resultats de la cerca
Mostrant coincidències amb:
-
Congrés sobre comunicació, desenvolupament i drets humans
18 de nov. 2015
Els pròxims dies 19 i 20 de novembre, la Facultat de Ciències de la Comunicació acull un congrés internacional on es discutirà sobre comunicació,...

-
Neix la major xarxa d'infraestructures científiques europees en nanociència
17 de nov. 2015
El projecte NFFA-Europe agrupa vint centres de recerca, laboratoris i universitats punters en la investigació en aquest camp, entre ells els que formen part...

-
Presenten els darrers avenços per a l'anàlisi de microorganismes alimentaris
12 de nov. 2015
El 24 de novembre comença la XIV edició del workshop sobre Mètodes Ràpids i Automatització en Microbiologia Alimentària (MRAMA). Organitzada pel CERPTA i del...
-
SomAtents impulsa dues iniciatives culturals per donar visibilitat a la identitat del Raval
11 de nov. 2015
SomAtents ha estrenat recentment al MACBA el documental "La roba estesa", sobre el rumbero Joan Ximénez Valentí el Petitet i l'Orquestra Simfònica de la...

-
Presenten l'Agenda per a la innovació i la competitivitat catalana 2015-2020
11 de nov. 2015
La Plataforma Coneixement, Territori i Innovació (CTI) organitza cada any seminaris internacionals amb representants dels mons acadèmic i empresarial. El...

-
Experts en dret mercantil debaten sobre disseny, distribució i marques
09 de nov. 2015
El Centre d’Economia Industrial organitza un any més la Jornada sobre Dret de la Propietat Industrial el proper 12 de novembre a Barcelona. Aquesta és la...

-
"Espanya és un laboratori mundial dels moviments socials"
06 de nov. 2015
Thomas Tufte, professor de la Roskilde University (Dinamarca) i expert mundial en el concepte de Communication per al Desenvolupament i Canvi Social (CDCS),...

-
Go! Go! Pixel + Almost Human: el màster en Videojocs de la UAB presenta els últims projectes
04 de nov. 2015
Divendres 6 de novembre, a les 18h, a l'Escola d'Enginyeria del campus UAB, es presenten els treballs de fi de màster de la darrera edició del màster en...

-
2a edició 2015 del curs sobre emprenedoria subvencionat per l'EOI
26 d’oct. 2015
El curs va dirigit a tot l'estudiantat del campus UAB i ofereix la possibilitat de formar-se gratuïtament en emprenedoria. Les inscipcions estaran obertes...

-
Debaten sobre transferència de coneixement de la universitat a la societat
23 d’oct. 2015
Diferents especialistes del camp de la investigació del Parc de Recerca de la UAB, del Barcelona Institute of Science and Technology i de l'empresa Bionure...
